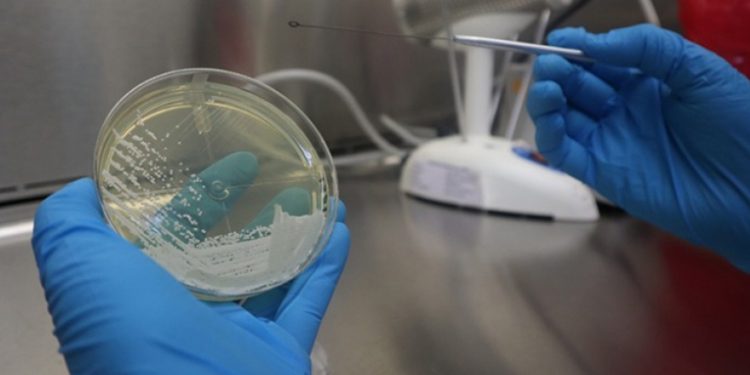
Alerta epidemiológica por peligroso hongo

2021-02-10
Nuevo Mundo – 96.1
Según las autoridades de la cartera de Salud, a finales del mes de enero fue emitida una alerta epidemiológica dirigida a Laboratorios, hospitales públicos y privados y Áreas de Salud, por el primer hallazgo de Candida Auris en Guatemala.Según la página oficial del Ministerio de Salud, Candida Auris es una levadura u hongo emergente, que es capaz de colonizar y causar infecciones profundas en órganos y tejidos de pacientes inmunosuprimidos (cuando se reduce su capacidad para combatir infecciones) o con su sistema inmunológico debilitado, sin embargo, el texto también indica que es considerado peligroso debido a su alta resistencia a los medicamentos antifúngicos, diseñados para tratar infecciones por hongos.Las autoridades indican que el contagio de este hongo se da principalmente en ambientes hospitalarios por lo que advierten a la población para que se informe.Primer HallazgoDurante el mes de diciembre de 2020, el hongo Candida Auris fue detectado en un paciente de género masculino de 32 años, que ingresó al Hospital Roosevelt por una infección en la tibia derecha. Al ser analizada la muestra por parte de las autoridades, el hongo fue aislado.El Laboratorio del Hospital San Juan de Dios fue la institución que confirmó el Candida Auris y posteriormente fue comunicado por Laboratorio Nacional de Salud.
Según las autoridades de la cartera de Salud, a finales del mes de enero fue emitida una alerta epidemiológica dirigida a Laboratorios, hospitales públicos y privados y Áreas de Salud, por el primer hallazgo de Candida Auris en Guatemala.
Según la página oficial del Ministerio de Salud, Candida Auris es una levadura u hongo emergente, que es capaz de colonizar y causar infecciones profundas en órganos y tejidos de pacientes inmunosuprimidos (cuando se reduce su capacidad para combatir infecciones) o con su sistema inmunológico debilitado, sin embargo, el texto también indica que es considerado peligroso debido a su alta resistencia a los medicamentos antifúngicos, diseñados para tratar infecciones por hongos.
Las autoridades indican que el contagio de este hongo se da principalmente en ambientes hospitalarios por lo que advierten a la población para que se informe.
Durante el mes de diciembre de 2020, el hongo Candida Auris fue detectado en un paciente de género masculino de 32 años, que ingresó al Hospital Roosevelt por una infección en la tibia derecha. Al ser analizada la muestra por parte de las autoridades, el hongo fue aislado.
El Laboratorio del Hospital San Juan de Dios fue la institución que confirmó el Candida Auris y posteriormente fue comunicado por Laboratorio Nacional de Salud.